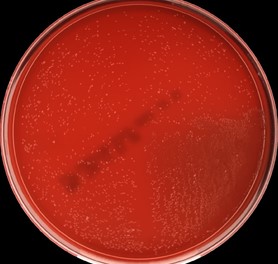

Case History
A middle age male with a past medical history of liver cirrhosis presented to the emergency department with one day of fever, chills, generalized weakness, and nausea. Complete blood count with differential showed leukopenia and neutropenia. Infectious work up was initiated including collection of 2 sets of blood cultures and imaging studies. A computed tomography (CT) scan of the abdomen revealed an irregularly shaped hypodense lesion in the right hepatic lobe concerning for abscess (Image 1). Ultrasound guided aspiration for the hepatic lesion yielded cloudy yellow bilious fluid, which was sent to the microbiology lab for aerobic and anaerobic cultures.

Two sets of blood cultures turned positive and Gram stain showed slender Gram positive rods in chains (Image 2). The aspirated fluid culture also showed 4+ Gram positive rods. Small gray colonies appeared on blood agar, chocolate agar, and Columbia Naladixic Acid (CNA) agar from both specimen types (Image 3). Lactobacillus rhamnosus was identified by matrix-assisted laser desorption/ionization time-of-flight mass spectrometry (MALDI-TOF MS). Minimal inhibitory concentration (MIC) was determined by broth microdilution assay and the organism was susceptible to penicillin while resistant to vancomycin. With appropriate antibiotics and abscess drainage, the patient’s condition improved and he was discharged to home.

Discussion
Lactobacillus species are facultatively anaerobic, gram positive, non-spore forming rods that can have varying Gram stain morphology including short plump rods or long slender rods in chains or palisides.1 Lactobacillus species are bacterial inhabitant of the human mouth, gastrointestinal tract, and female genital tract. Isolation from clinical specimens could be considered by many to have questionable clinical significance.2 Lactobacillus species are often present in probiotics and fermented dairy products, including yogurt, and have been reported to provide benefits in gastrointestinal health,3–5 which led to increase in consumption of these products by many people, including our patient.
Cases of liver abscess and bacteremia caused by Lactobacillus species have been rarely reported in the literature and risk factors for the infection were immunosuppression, uncontrolled diabetes, hepatopancreaticobiliary disease, bacterial translocation, and use of probiotics or heavy dairy product consumption.6,7 The causative strains included L. rhamnosus, L. acidophilus, and L. paracasei.7
Pathophysiology of liver abscess and bacteremia due to Lactobacillus species is not well understood but it is postulated that several mechanisms may contribute to the pathogenicity of lactobacilli. Some strains are able to bind to intestinal mucosa, which may aid in translocation of the organism into the bloodstream. Also some strains can adhere to extracellular matrix proteins, aggregate platelets, and produce glycosidases and proteases.7 Furthermore, some strains are more resistant to intracellular killing by macrophages and nitric oxide.8
It is worth noting that many species of Lactobacillus are intrinsically resistant to vancomycin. However, they are usually susceptible to penicillin and ampicillin, as it was seen in our patient, and antimicrobial susceptibility testing can be performed by determining MIC of antimicrobials.9
References
- Goldstein EJC, Tyrrell KL, Citron DM. Lactobacillus Species: Taxonomic Complexity and Controversial Susceptibilities. Clin Infect Dis. 2015;60(suppl_2):S98-S107. doi:10.1093/CID/CIV072
- Chan JFW, Lau SKP, Woo PCY, et al. Lactobacillus rhamnosus hepatic abscess associated with Mirizzi syndrome: a case report and review of the literature. Diagn Microbiol Infect Dis. 2010;66(1):94-97. doi:10.1016/J.DIAGMICROBIO.2009.08.009
- Kligler B, Cohrssen A. Probiotics. Am Fam Physician. 2008;78(9):1073-1078. Accessed November 17, 2021. http://www.aafp.org/afp.
- Anukam KC, Osazuwa EO, Osadolor HB, Bruce AW, Reid G. Yogurt containing probiotic Lactobacillus rhamnosus GR-1 and L. reuteri RC-14 helps resolve moderate diarrhea and increases CD4 count in HIV/AIDS patients. J Clin Gastroenterol. 2008;42(3):239-243. doi:10.1097/MCG.0B013E31802C7465
- Adolfsson O, Meydani SN, Russell RM. Yogurt and gut function. Am J Clin Nutr. 2004;80(2):245-256. doi:10.1093/AJCN/80.2.245
- Omar AM, Ahmadi N, Ombada M, et al. Breaking Bad: a case of Lactobacillus bacteremia and liver abscess. J Community Hosp Intern Med Perspect. 2019;9(3):235. doi:10.1080/20009666.2019.1607704
- Sherid M, Samo S, Sulaiman S, Husein H, Sifuentes H, Sridhar S. Liver abscess and bacteremia caused by lactobacillus: Role of probiotics? Case report and review of the literature. BMC Gastroenterol. 2016;16(1):1-6. doi:10.1186/S12876-016-0552-Y/TABLES/1
- Asahara T, Takahashi M, Nomoto K, et al. Assessment of Safety of Lactobacillus Strains Based on Resistance to Host Innate Defense Mechanisms. Clin Diagn Lab Immunol. 2003;10(1):169. doi:10.1128/CDLI.10.1.169-173.2003
- CLSI. M45. Methods for Antimicrobial Dilution and Disk Susceptibility Testing of Infrequently Isolated or Fastidious Bacteria ; Proposed Guideline. Vol 35.; 2015. Accessed November 17, 2021. http://www.clsi.org.

–Do Young Kim, MD is a medical microbiology fellow at University of Chicago (NorthShore). His academic interests include clinical microbiology and infectious diseases, epidemiology, and public health.

-Paige M.K. Larkin, PhD, D(ABMM), M(ASCP)CM is the Director of Molecular Microbiology and Associate Director of Clinical Microbiology at NorthShore University HealthSystem in Evanston, IL. Her interests include mycology, mycobacteriology, point-of-care testing, and molecular diagnostics, especially next generation sequencing.
Thanks ,I will study them All. My warmth regards. God Bless.